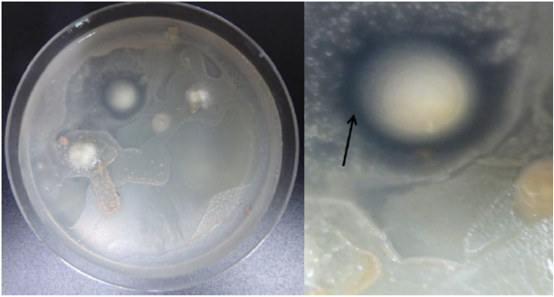
圖片關(guān)鍵詞 圖片關(guān)鍵詞

為什么腐生真菌具有極好的藥用特性
真菌王國是一個(gè)令人難以置信的奇妙生物群。真菌種類多達(dá)10萬種以上,每年都有數(shù)以千計(jì)的新物種被描述。通過使用現(xiàn)代遺傳技術(shù)(PCR和RFLP),我們可以非常準(zhǔn)確地對新物種進(jìn)行鑒定或分類,因此它們的數(shù)量還會(huì)不斷增加,估計(jì)約有150萬種。
大型真菌一般由兩部分組成,其營養(yǎng)部分稱為菌絲體,是由菌絲交織成的網(wǎng)狀結(jié)構(gòu);其生殖(有性)部分稱為子實(shí)體,真菌主要通過子實(shí)體為大家所認(rèn)知。
根據(jù)營養(yǎng)供應(yīng)類型,真菌可分為3類:(1)寄生型——需要活細(xì)胞。它們是寄生在植物、動(dòng)物(包括人類)以及真菌上的真菌病原體。(2)共生型——與植物的根有關(guān)。這一類型真菌被稱 為菌根菌。(3)腐生型——從死亡的有機(jī)物質(zhì)中獲取營養(yǎng)。
圖 1 平菇菌絲體抑制細(xì)菌生長
腐生菌(木腐菌)具有最有效的藥用特性。原因在于它們獨(dú)特的消化方式——溶養(yǎng)(Lysotrophy)。 它們生活在各種死去的有機(jī)物質(zhì)上,分泌消化酶——胞外酶(溶酶)到這些物質(zhì)中,消化過程發(fā)生在細(xì)胞外(體外)。胞外酶的連續(xù)活動(dòng)將有機(jī)物分解成簡單物質(zhì)。細(xì)胞外腐化過程的最終產(chǎn)物是葡萄糖,然后葡萄糖被吸收到菌絲細(xì)胞中進(jìn)行自身的新陳代謝,合成菌絲體和子實(shí)體生長所需的特定物質(zhì)。然而,基質(zhì)中的葡萄糖也可以被大量的其他微生物利用,這些微生物是真菌獲取“溶養(yǎng)型”葡萄糖的競爭者。
為了保護(hù)葡萄糖不被競爭對手侵占,腐生真菌將次生代謝產(chǎn)物作為防御化合物釋放到基質(zhì)中以控制競爭對手(圖1)?;|(zhì)中競爭微生物種類的繁多反映在真菌次生代謝產(chǎn)物的多樣性上。因此,真菌代謝產(chǎn)物復(fù)雜而高度多樣化,包括多糖、蛋白質(zhì)、萜類化合物、皂苷、甾醇類、聚酮類化合物(黃曲霉毒素B1)、酚類、凝集素他汀類藥物、生物堿類等。藥用菌的次生代謝物具有廣泛的生物活性,攝入后對人體微生物有類似的作用。因此,藥用菌的治療作用很廣泛,其次生代謝產(chǎn)物有助于緩解多種疾病。
然而,當(dāng)前對腐生菌的研究還不夠深入,特別是菌絲體及其生理機(jī)制。了解菌絲生長的生理機(jī)制對于真菌的培養(yǎng)和具有藥用價(jià)值的化合物的生產(chǎn)至關(guān)重要。為此,我們在實(shí)驗(yàn)室條件下研究了一些最常見的白腐真菌菌絲間的相互作用。通過對“離體”木腐菌的研究發(fā)現(xiàn),不同木材腐殖菌之間的關(guān)系可以表現(xiàn)為協(xié)同、中立、占領(lǐng)或拮抗的作用(圖 2)。
木材上的假菌核(“區(qū)域線”)就是不 同種類木腐菌之間拮抗作用結(jié)果的典型 例子(圖 3)。“區(qū)域線”是一種特殊的白腐 病,發(fā)生在木材同時(shí)感染幾種真菌的部位 它是由基材的分解不均勻造成,反映為受感染木材的典型的彩色外觀。分解區(qū)域因 排出的次級代謝產(chǎn)物影響而產(chǎn)生的黑色 區(qū)域線。不同菌種的拮抗組合,形成了基 材的顏色。

圖 2 不同種類木材腐朽真菌相互作用

圖 3 “區(qū)域線”
我們發(fā)現(xiàn),兩種真菌在固體培養(yǎng)基上組合培養(yǎng)會(huì)形成抑菌圈,并能對著生的木材樣品進(jìn)行染色,尤以裂褶菌(Schizophyllum commune)/紫韌革菌(Chondrostereum purpureum)組合的基質(zhì)著色力最強(qiáng)。這表明拮抗真菌產(chǎn)生抗真菌次生代謝產(chǎn)物,并通過培養(yǎng)基向木材基質(zhì)擴(kuò)散。我們在不同的對真菌的浸沒培養(yǎng)物中觀察到相同的現(xiàn)象:其液體培養(yǎng)基均被染色,有藍(lán)色、黃色、棕色等。表明真菌通過相互作用,將次生代謝產(chǎn)物釋放到固體、液體生長培養(yǎng)基以及作為雙菌絲培養(yǎng)物的木材樣品上。
從兩種菌絲培養(yǎng)物的抑菌圈和純菌絲培養(yǎng)物中,我們提取代謝物并采用高效液相色譜法(HPLC)進(jìn) 行分析,結(jié)果峰值只出現(xiàn)在雙菌絲培養(yǎng)的抑菌圈區(qū)域。無論由哪兩種真菌種類進(jìn)行組合,在相同的保留 時(shí)間,其抑菌圈均出現(xiàn)相同的峰值。這意味著不同的真菌物種“說”同一種語言。

圖 4 提取的真菌代謝產(chǎn)物能抑制其他真菌的菌絲生長
同時(shí),我們還證明了從裂褶菌/云芝[Trametes (Coriolus)]雙菌絲培養(yǎng)的抑菌圈上提取的代謝物可以抑制平菇(Pleurotus ostreatus)菌絲的生長(圖 4)。并從硫黃菌(Laetiporus sulphureus)子實(shí)體中提取出可抑制人類免疫缺陷病毒(HIV)酶活性的化合物。
此外,真菌次生代謝產(chǎn)物還具有多種其他生物作用,例如它們可以參與細(xì)胞信號傳導(dǎo)、黏附和真菌發(fā)育等過程。次生代謝產(chǎn)物平菇素,是一種來自平菇的蛋白質(zhì)。在生長過快的平菇菌絲表面施用平菇素,對菌絲生長僅有輕微的抑制作用,但能較強(qiáng)地誘導(dǎo)原基的形成,促進(jìn)原基向子實(shí)體發(fā)育。
由于真菌競爭能誘導(dǎo)(刺激)次生代謝產(chǎn)物的合成,因此我們建議醫(yī)學(xué)上對藥用真菌采用混合培養(yǎng)方式,以獲得具有更高治療價(jià)值的化合物。
本文為Franc Pohleven 教授在第十屆國際藥用菌大會(huì)上的演講稿,經(jīng)其同意,由《食藥用菌》編輯部鄭玲翻譯整理成文,并發(fā)表于《食藥用菌》, 2019(6)。
